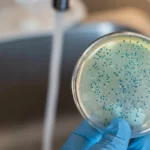
bacterias (7)

Top 3 Indicators of Elevated Copper in Water
- Published:
- Updated: December 27, 2024
Summary
Elevated copper levels in drinking water can pose serious health risks, including gastrointestinal issues, liver damage, and birth defects. Recognizing indicators such as discoloration of fixtures, metallic taste, and blue-green stains is crucial. Regular testing and implementing water treatment systems are vital for safeguarding health.
- Discoloration of plumbing fixtures
- Metallic taste in water
- Blue-green stains on plumbing fixtures
Copper is a crucial mineral which can keep you in good health. But copper in the water is a very serious health risk and a sign of a faulty supply. If you have elevated copper in your water, know the signs and symptoms of copper, and act to save your health.
What are the health effects of elevated copper levels in drinking water?
The gastrointestinal issues that can be caused by the high copper concentrations in drinking water include nausea, vomiting and diarrhoea. The liver and kidneys are also damaged by prolonged consumption of high levels of copper, and cancers of some kinds can develop from chronic consumption. Plus, too much copper can damage the foetus, causing birth defects and deformed development.
Keep in mind that symptoms of copper overdose in drinking water can mimic many other health problems, so get your water tested if you think your water is potentially poisonous.
What are the top 3 indicators of elevated copper levels in drinking water?
- Discoloration of plumbing fixtures: One of the most obvious signs of elevated copper levels in drinking water is a blue-green discoloration of plumbing fixtures, such as sinks, toilets, and bathtubs. This discoloration is caused by corrosion of the fixtures, which can release copper into the water.
- Metallic taste in water: Another indicator of elevated copper levels in drinking water is a metallic taste in the water. If your water has a strong, metallic taste, it may be a sign that the levels of copper in your drinking water are too high.
- Blue-green stains on plumbing fixtures: In addition to discoloration of plumbing fixtures, elevated copper levels in drinking water can also cause blue-green stains to appear on plumbing fixtures. These stains are caused by the buildup of copper salts on the fixtures, and they can be difficult to remove.
It’s important to note that elevated copper levels in drinking water can cause a variety of other symptoms and health problems, so it’s important to have your drinking water tested if you suspect that your water may be contaminated.
How can you protect yourself and your family from the potential health risks associated with high levels of copper in your drinking water?
Here are a few things you can do to help yourself and your family avoid the health risk posed by excess copper in your water:
You Need to Test Your Drinking Water: If you think that your drinking water has high copper levels, you should get your water tested. A water testing lab can test your water and figure out the copper, etc levels in your water.
3) Install a water treatment system: If you have copper contamination in your drinking water that’s too high, then you might need a water treatment system. There are water filtration, reverse osmosis, and ion exchange systems for you to choose from.
Fix broken copper plumbing pipes: If your plumbing pipes are rusting and spewing copper into your water, you might need to replace them with something else like plastic or stainless steel.
Get a water softener: If your water is hard and your plumbing fixtures are corroding, then your water can be softened by the water softener to neutralize the copper from your water by extracting the minerals that are corroding the pipes. Water softener: A water softener is a device that replaces minerals in water (calcium, magnesium) with sodium. It dries out the water and keeps the plumbing fixtures from getting corrosion.
Do not use copper products: If you’re worried about high copper concentrations in your water, then do not use copper-based products (for example, cookware, water bottles) at all. Rather, get things that are made of different materials like stainless steel or glass.
Know where your water gets its copper: Knowing where your water gets its copper is a good place to start when deciding how to protect yourself and your family from potential illnesses resulting from copper high levels in your water. Some copper traces in water are corrosion of pipes, corrosion control chemicals and leaching from copper products.

The Importance of Regular Water Testing
Copper testing for school water should be performed regularly to keep the copper and other contaminants in school drinking water within safe ranges. We need these tests as they are going to tell us if there is anything wrong with the water quality and give them time to rectify it before it gets to a health hazard.
The recommended testing of school water for copper in the water supply is every year, or sooner if it is suspected that the water has copper. You can test this by certified water testing labs or by using home water testing kits. But professional lab testing is generally more accurate than home tests. So if you are worried about copper in the water then it is better to go for a professional school water test to make sure the results are accurate and credible. When schools invest in conducting frequent and thorough copper testing of school water, the wellbeing of the students and employees can be kept well-protected.
Share this on social media: